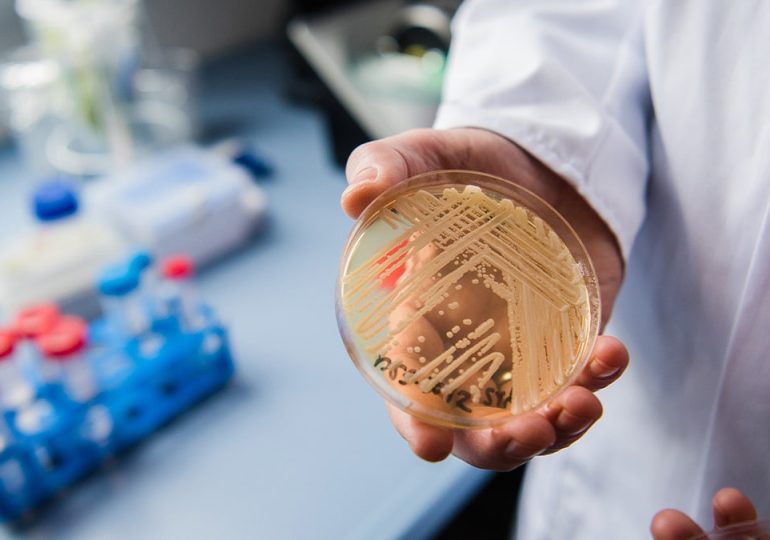
Deadly 'superbug' is spreading across US as drug resistance grows, researchers warn

NEWYou can now listen to Fox News articles! Cybercriminals don’t always need malware or exploits to break into systems anymore. Sometimes, they just need the right words in the right…
Day: January 4, 2026
Second front: How a socialist cell in the US mobilized pro-Maduro foot soldiers within 12 hours
NEWYou can now listen to Fox News articles! As the U.S. military carried out a daring operation to capture Venezuela’s Nicolás Maduro, a second front opened up within minutes in…
Deadly 'superbug' is spreading across US as drug resistance grows, researchers warn
NEWYou can now listen to Fox News articles! A deadly, drug-resistant fungus already spreading rapidly through U.S. hospitals is becoming even more threatening worldwide, though there may be hope for…